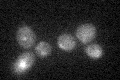
YHL047C

View description
Transporter, member of the ARN family of transporters that specifically recognize siderophore-iron chelates; responsible for uptake of iron bound to the siderophore triacetylfusarinine C
Localization:
Intensity:
Fold change:
Significance:
-
C’ GFP library in SD

below threshold15.84 -
N' NOP1pr-GFP in SD

vacuole59.4286 -
N' TEF2pr-mCherry in SD

vacuole94.8622 -
N' NATIVEpr-GFP in SD

below threshold15.576 -
N' TEF2pr-VC and Cyto-VN in SD

below threshold24.4877 -
C’ GFP library in SD+DTT

cytosol14.620.92No -
C’ GFP library in SD+H2O2
cytosol15.520.97No -
C’ GFP library in Starvation Media

cytosol16.561.04No -
C’ GFP library on the background of Pup2-DaMP

below threshold -
C’ GFP library on the background of CCT mutant

below threshold14.5360.917113No
